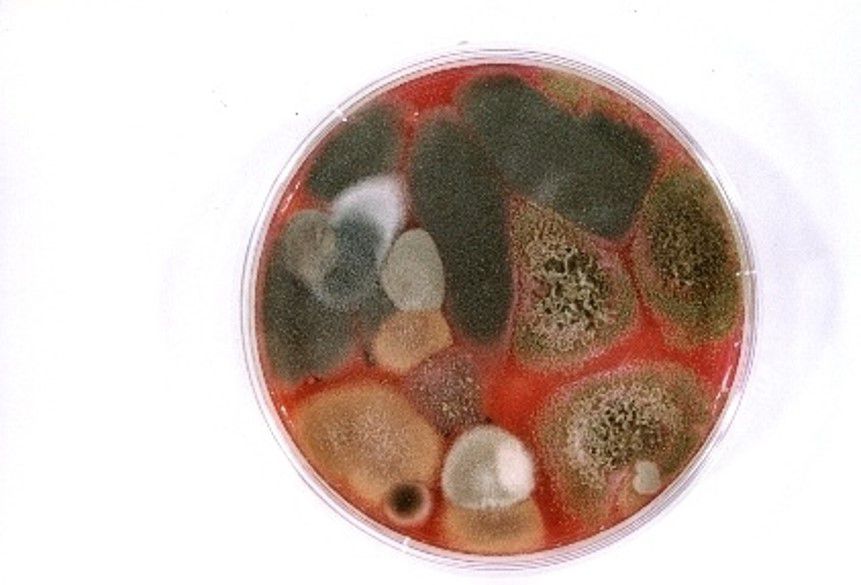

Air Et Bio à Chambéry 73000 : Adresse, horaires, téléphone
Spécialiste de la qualité microbiologique de l'air.
Mesure des aérosols biologiques dans divers environnements, bureaux climatisés ou non, industrie, habitat.
Audits environnementaux basés sur des mesures objectives pour diagnostiquer une contamination microbiologique, déterminer l'exposition des personnes et le danger médical et environnemental, et détecter une cause afin d'y remédier. Approche à la fois médicale biologique environnementale et technique. Propositions d'actions correctives et préventives.
Etudes d'efficacité de matériels (épurateurs d'airs, filtres) sur aérosols biologiques.
Voir le site
Horaires
Les horaires d’ouverture de Air Et Bio, sont fournis à titre informatif, hors périodes de congés. Pour être certain de ces horaires, veuillez contacter directement l’établissement.
- Lundi
09:00-19:00
- Mardi
09:00-19:00
- Mercredi
09:00-19:00
- Jeudi
09:00-19:00
- Vendredi
09:00-19:00
- Samedi
Fermé
- Dimanche
Fermé
la proposition a été envoyée
Langues parlées
- fr
Nos Offres Pro